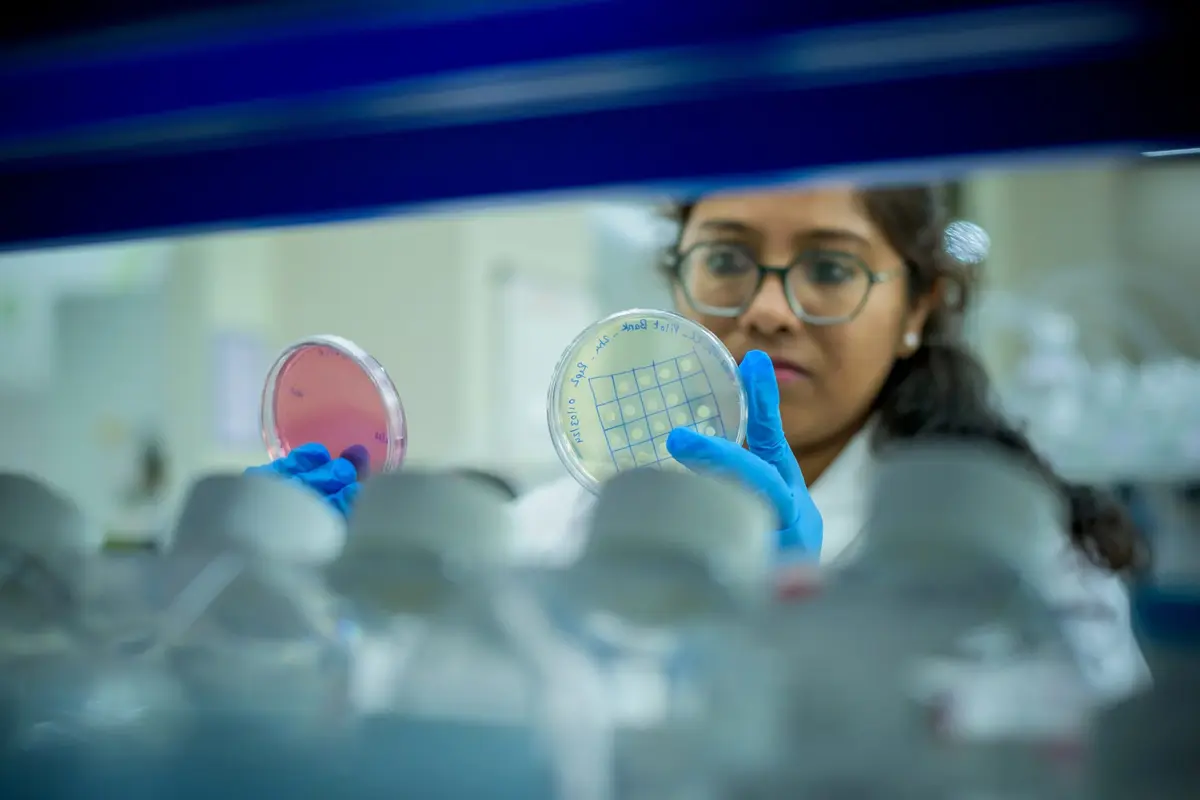

Therapeutic recombinant proteins
Streamline your therapeutic recombinant protein production with our custom development and manufacturing solutions.
Why develop recombinant proteins?
Recombinant proteins are a rapidly growing class of drugs that offer significant potential for the treatment of a wide range of diseases, including cancer, autoimmune disorders and myocardial infarction. These proteins are produced using recombinant DNA technology, allowing for the precise manipulation of genes and the expression of specific proteins in a controlled environment using living organisms as a host.
We can support you in producing large quantities of pure, well-defined recombinant proteins to help bring your innovative therapies to life.
Challenges in recombinant protein production
The production of protein-based drugs presents several challenges:
- Complex manufacturing process: Protein drugs are typically produced using living cells or organisms, requiring careful selection of the cell line, species origin and culture conditions
- Post-translational modifications: Most biologically active proteins require specific post-translational modifications, which can be difficult to achieve in heterologous expression systems
- Purification: Protein drugs must undergo complex purification processes to remove impurities and ensure product quality
- Viral clearance: Viral contamination poses a significant safety concern, requiring the implementation of viral clearance processes such as filtration, resins, low pH, or detergents
Understanding our recombinant protein production
With our expertise in handling protein-based therapeutics, we can help you overcome development and manufacturing challenges to design and deliver efficacious and safe therapeutic products.
Our capabilities include:
- Development of bench-scale process and scale-up for purification of recombinant proteins from E. coli, yeast and mammalian expression systems
- Development of novel refolding methods from inclusion bodies for high recovery
- Application of multiple chromatographic columns for purification (e.g. ion exchanges, hydrophobic interaction, affinity, ceramic hydroxyapatite, metal-chelate, gel permeation, reverse phase, mixed-mode chromatography)
- Analytical method development and customization for efficient analysis
Our fully validated and patented continuous bioprocess manufacturing platform, EnzeneX®, can also provide efficient, high-quality and cost-effective production.

Why partner with Enzene for recombinant proteins?
We are a global CDMO and biosimilar developer dedicated to impacting the global healthcare landscape by bringing trusted and affordable medicines to market, quickly.
We understand that each modality has unique requirements, and we are committed to providing you with the highest quality products and services. Our flexible development and manufacturing platforms allow us to quickly and efficiently produce modalities, regardless of their complexity or scale.
Our proprietary continuous bioprocess manufacturing platform, EnzeneX® further enhances production, with accelerated rates and a significant reduction in the cost of producing complex modalities — from mAbs to complex proteins.
Related case studies
Latest resources
A modality for every need
Fueled by our continuous innovation and armed with our wide variety of modalities, we are dedicated to bringing your biologics innovations to life.